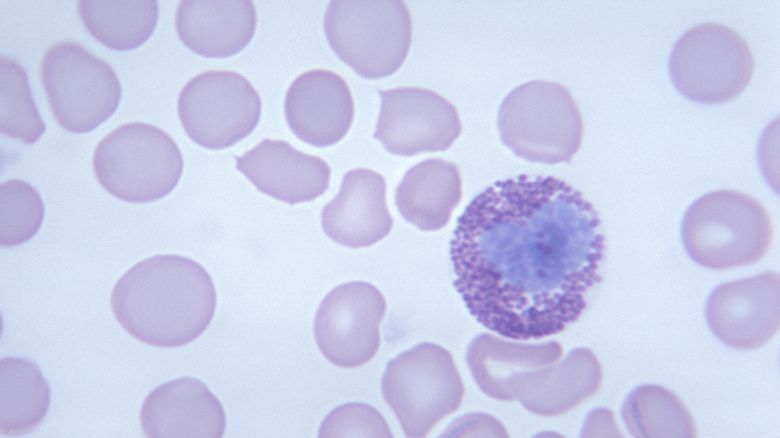

Circa 130.000 persone in Italia convivono con la forma più diffusa di linfoma, quello definito come “non Hodgkin”, il sesto per diffusione nel mondo occidentale e il quinto in Europa, eppure ancora poco conosciuto dalla popolazione generale.
La campagna “Ritorniamo al Futuro – Più tempo contro il linfoma”, promossa dall’Associazione nazionale Banche del Tempo e da Roche, vuole spostare indietro di due ore le lancette degli orologi, per guadagnare simbolicamente un po’ di tempo soprattutto per chi è affetto da questo male.
Fai la tua domanda ai nostri esperti

Ogni anno il 15 settembre si celebra la Giornata Mondiale per la conoscenza del linfoma: i linfomi sono malattie proliferative del tessuto linfatico, ubiquitario in diverse parti del corpo, motivo per cui, le sedi di insorgenza e di diffusione possono essere varie, anche se uno dei siti di sviluppo preferenziale è costituito dai linfonodi.
Vi sono due tipi principali di linfomi: linfoma di Hodgkin (HL) e linfoma non-Hodgkin (NHL), a cui si aggiungono il mieloma multiplo e la malattia immunoproliferativa, inclusi dall’Organizzazione Mondiale della Sanità nella seconda categoria.
I linfomi non-Hodgkin costituiscono circa il 90% dei casi e comprendono un gran numero di sotto-tipi: proprio a ridosso della giornata mondiale per la conoscenza del linfoma continua anche la campagna itinerante informativa “più tempo contro il linfoma”.
La campagna ha anche lo scopo di far conoscere i progressi scientifici compiuti negli ultimi vent’anni, con una serie di innovazioni che hanno aumentato notevolmente le possibilità di guarigione, oltre a ridurre drasticamente gli effetti collaterali delle cure.

Il linfoma non-Hodgkin rappresenta la patologia che, nel campo delle neoplasie oncologiche ed ematologiche, ha ottenuto i maggiori progressi in termini di percentuale di pazienti guariti e di remissione della malattia: circa il 50-55% nei linfomi aggressivi e il 20-25% in quelli indolenti.
Alcuni dei trattamenti per questo tipo di tumore si possono ricevere in day hospital e questo permette ai medici che devono effettuare la terapia di avere più tempo a disposizione per accogliere il paziente, ascoltarlo, tranquillizzarlo e metterlo a proprio agio.

In Italia un terzo della popolazione non ha mai tempo e ne vorrebbe di più per sé. Oggi il tempo è denaro ed è considerato come un vero bene di lusso: per avere due ore in più in una giornata, il 35% delle persone rinuncerebbe a un gioiello importante (al primo posto per il 5% del campione), ad un’automobile (12%) e perfino alla possibilità di fare un bel viaggio (46%).
Il tempo influisce direttamente sulla qualità della vita delle persone e ancora di più su quella dei pazienti gravati da malattie.

«Negli ultimi 15-20 anni, l’immunochemioterapia, cioè l’associazione tra chemioterapia e anticorpi monoclonali, ha permesso di registrare un notevole miglioramento in termini di diminuzione della mortalità – spiega Pietro Leoni, Professore di Ematologia, Dipartimento di Scienze Cliniche e Molecolari, Clinica di Ematologia, Università Politecnica delle Marche – I nuovi trattamenti, inoltre, vanno nella direzione di un enorme risparmio di tempo nella somministrazione della terapia: è il caso, ad esempio, della formulazione sottocutanea di rituximab».

«Se inizialmente il trattamento necessitava anche di 4 o 5 ore, in seguito il tempo di somministrazione si è ridotto a circa 2 ore e finalmente oggi è possibile somministrarlo in pochi minuti – prosegue l’esperto – È evidente il vantaggio organizzativo per le strutture ospedaliere che riducono le attese in Day-Hospital, ma a questo vantaggio pratico se ne aggiunge anche uno qualitativo: medici e infermieri possono dedicare più tempo all’accoglienza del paziente per ascoltarlo, tranquillizzarlo e metterlo a proprio agio. Dare valore al tempo significa umanizzare la terapia».


